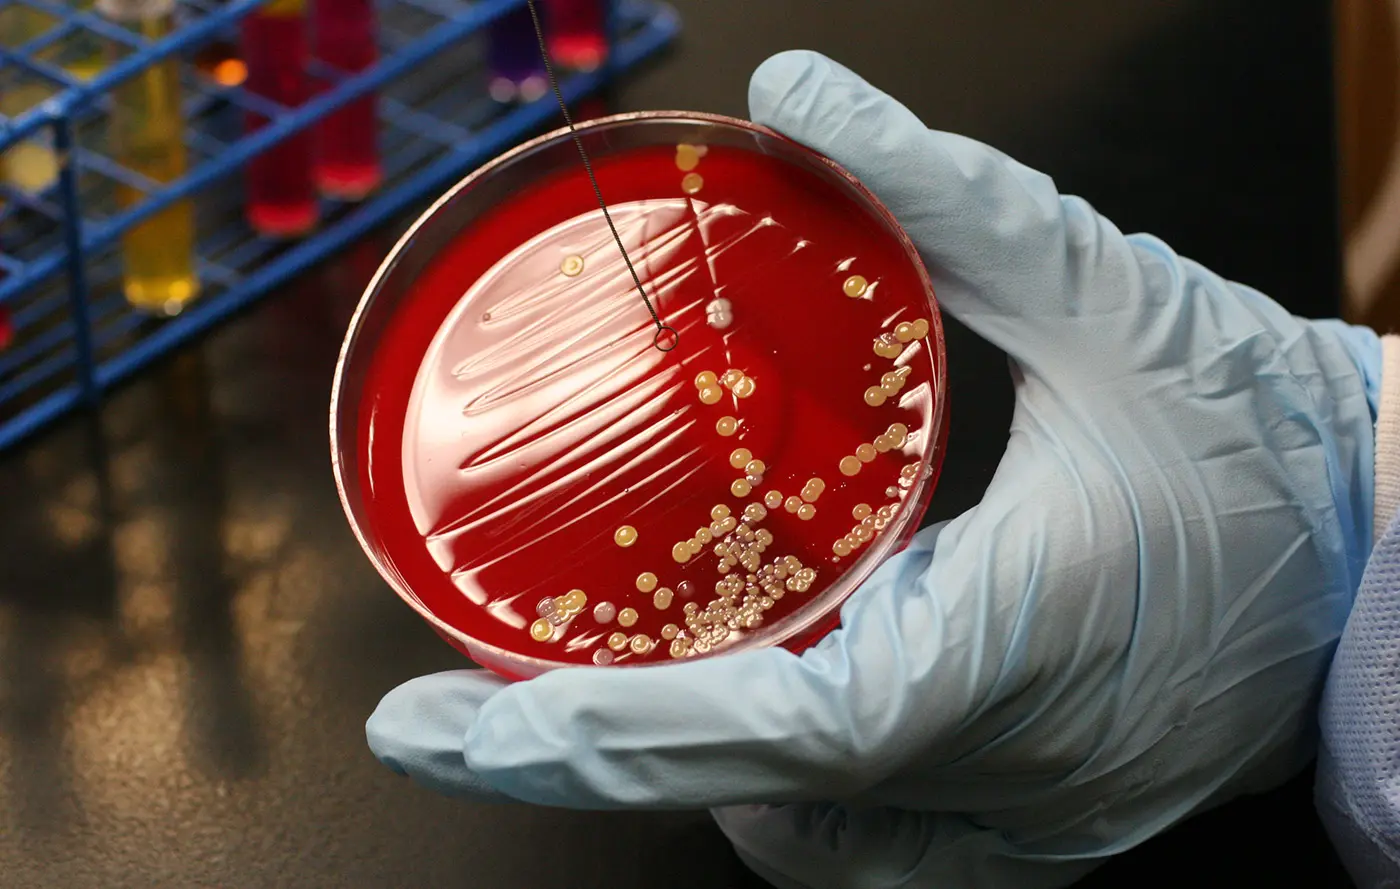
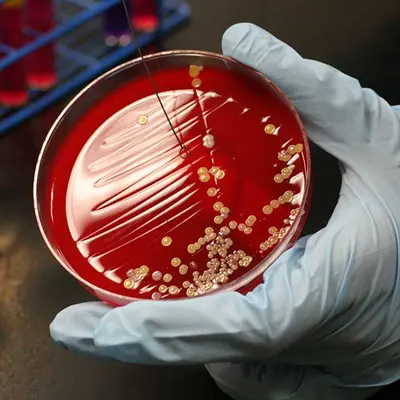

Biology Professor Recognized with NSF CAREER Award for Epigenetics Research
Assistant Professor Teresa Lee of the Department of Biological Sciences has won a $1.1 million CAREER grant from the National Science Foundation to support her epigenetics research.